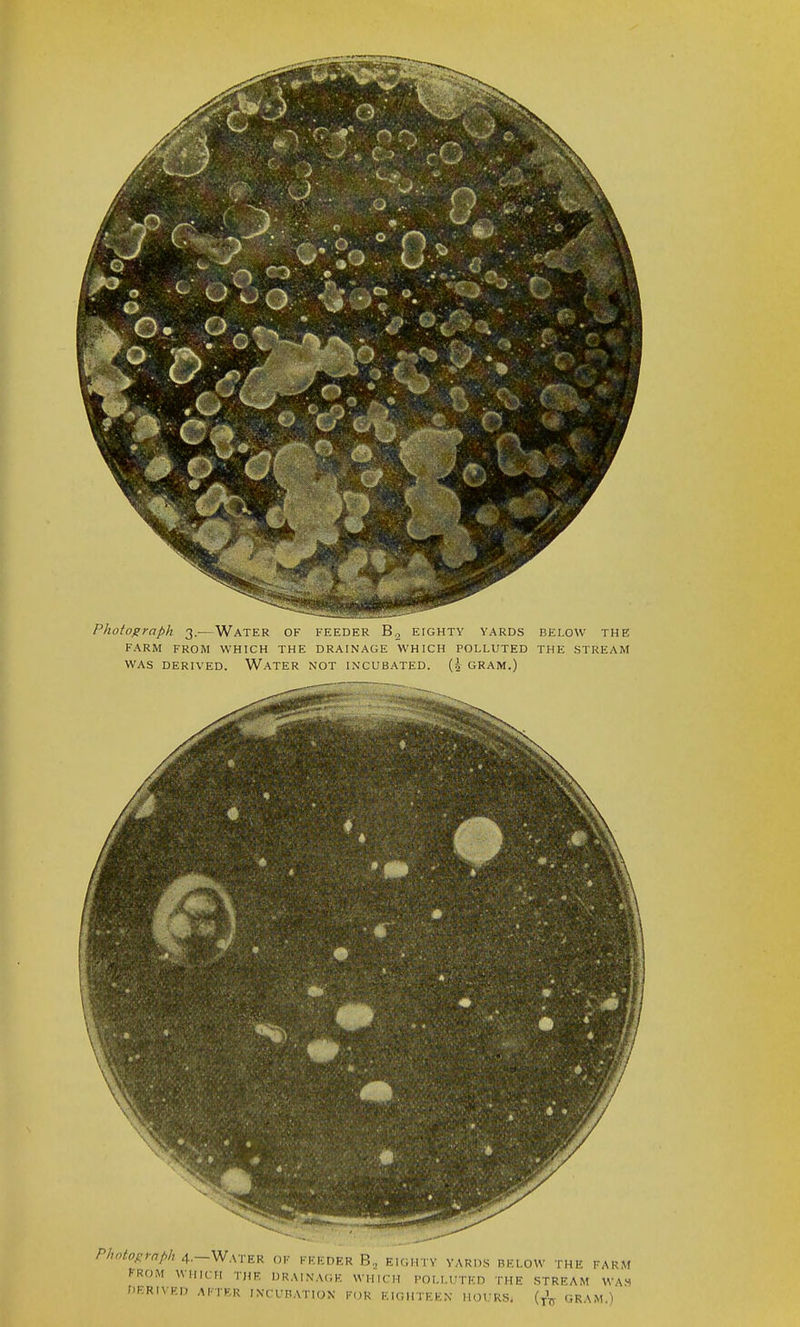
Photograph 3.—Water of feeder B2 eighty yards below the FARM FROM WHICH THE DRAINAGE WHICH POLLUTED THE STREAM WAS DERIVED. WATER NOT INCUBATED. (| GRAM.) Photograph 4.—Water of feeder B„ eighty yards below the farm rROM wine,, the drainage which polluted the stream was DERIVED AFTER INCUBATION FOR EIGHTEEN HOURS. (TV GRAM.)

Licence: Public Domain Mark
Credit: Bacteriological survey of "surface" water supplies. Source: Wellcome Collection.
Provider: This material has been provided by The University of Glasgow Library. The original may be consulted at The University of Glasgow Library.
25/40 page 25